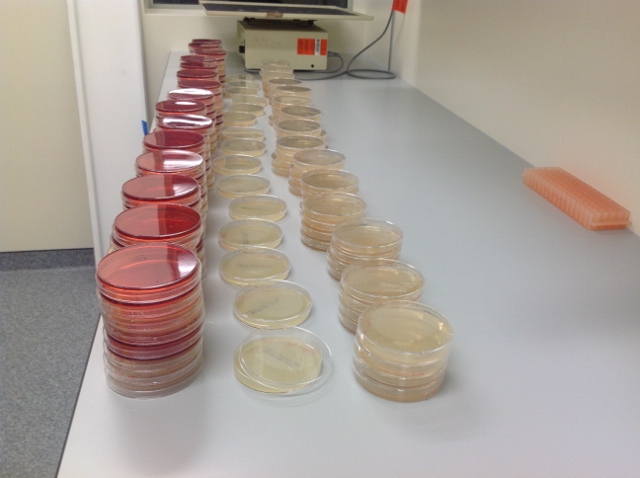

全25件 (25件中 1-25件目)
1

26日 今日は微生物教室で持ち寄りランチ、とのことで、朝でも作れるものを、と、赤しそ入りのおにぎりと、かぼちゃの煮物を作りました。ぶどうくんはなかなかおきてこないと思ったら赤い顔をしておきてきて、、、やっぱり37.2度ほどあったのでお休みに。で、幼稚園に電話してびっくりすることを知りました!熱の後は48時間来ちゃだめ、とのことだったんだけど、「熱」っていうのは38度からなんだって!37度ちょいですっていったら、「あ、それはノーマルです」だってさ!そうかあ、さすが生後一週間の赤ちゃんをつれまわす西洋式医学。。。37度はノーマルなのか。。。今日は大学では午前中はデータと格闘して、やっと作り直し終了。そしてお昼のランチパーティーに。うちの教室は、インド系がほとんどで、あとは中東系、中国人二人、と偏ったメンバーなので、料理は凄く中東っぽいものばかりでした。そして見事に炭水化物ばかり笑私のかぼちゃやおにぎりは、中国人たちには凄く人気で、インド人もすきだって言ってたな。でも人数に対して食べ物が多すぎて、みんな半分も食べられないで終わってしまいました。午後は昨日のデータをカウントして、後の時間はプレゼンのトークの内容を考えていたらあっという間。りんごを迎えにいって、聞いたことには、大会がもうすぐなのにグループの踊り、もう一年以上も同じようなのを練習してるんだけど、突然立ち位置が右から左に変わったそうで!超混乱でしかられてばかりいたらしい。。。そりゃ混乱するよね。。間に合うのかしら。。。買い物して帰宅して、今日の夕食は、買ってきたハニーソイの味がついている焼き鳥。美味しかったので子供たちが大量にご飯を食べました(^^;ぶどうくんは、荷物が届いてたのでもしかしてばあばからのお誕生日プレゼント!?と大喜びで郵便局にいったんだけど、学生ビザが届いてたんだって笑がっかりしてましたよ。夜、子供たちを寝かしつけた後ぶどう君の熱はぐんぐん上がり、、、苦しそうにしてるから抱っこして眠ったんだけど、多分38度以上あったなあ。パパの風邪が今頃移ったのかしら?やっぱり今こちらではやっているというマイコプラズマなのか!?咳がひどいからなあ。。。ブログランキングに登録してみました。 よかったらポチっとしてみてください(^^ ↓ にほんブログ村
2014年06月30日
コメント(2)

25日 今日は待っていたプレートが届いた!とのことで早速月曜の朝に取ってきた野菜の実験をすることに。午前中のうちに準備をして、大量に作ってあった寒天をプレートについで、午後には実験。早めに終わった後、データと格闘してあっという間に帰る時間。 家に帰ると今日もいつものメンバーが来ていました(^^ 5時半ごろには全員のお迎えが来て、夕食作り。 今日の夕食は、ひき肉と野菜の炒め物。 作ってあったセロリの漬物や、同じ味付けで大根の漬物は、生にんにくがきついとのことで 食べてもらえず。 さらに大量にあったパセリをどうしようと思ってたら、ネットでいいレシピを発見! これまた自分しか食べないので全部それにして見ましたよ。 しょうゆとマヨネーズと七味を、刻んだパセリに混ぜる、というものだったのだけど(分量なし) 七味はないので、チリとゴマを混ぜました。 確かに美味しい! ものすごくたくさんあったんだけど、、、どうせ誰も食べないし、と結局一人で全部平らげてしまいました。 炒め物のほうは大根を漬けた汁で味付けしたけど、こちらは美味しいと好評でしたよ。 最近双子は、親友のYちゃんからいろんなイスラム教の話を聞いているらしい。 ご飯食べられないときがあるんだって! 女の子はヨルダンではイスラム教やめると殺されるんだって! と、結構ヘビーな話題を教わっているらしい。 Yちゃんはあのベールをかぶるかかぶらないかはまだ決めてないんだって。 ママは、できればイスラムの人とは結婚してほしくないんだよね。。。 って言ったら、もちろんだよ!無理無理!とりんごは即答でしたが笑、 案外あの子のほうが、好きになっちゃったからしょうがないとか言って結婚したりしちゃいそうなんだよなー。 ブログランキングに登録してみました。 よかったらポチっとしてみてください(^^ ↓ にほんブログ村
2014年06月28日
コメント(2)

24日 今日はぶどう君も元気になって幼稚園へ。大学へ行って朝はいつものように過ごしていたら、先生がちょっとデータの検討をしよう、といってきました。実はデータ、、、昨日だったか、金曜だったかに気づいたんだけど、、、重大なミスをしていてね! 私、こんなんで科学者になれるのかって感じなんだけど、単位、が凄く苦手なんですよ。 物理が大嫌いだったのも、単位のせい。 あの単位の記号見ると生理的に受け付けないのよねー。。。笑という言い訳の元、、、ネットで、細菌の数の出し方を見て計算したんだけど、、、、 一グラム当たりに、とかいてあったのに、それを全く無視して計算してたんですよね笑なぜそれが発覚したかというと、例の中国人Cちゃんとデータを交換したから。ああ、気づけてよかった、と一生懸命直し始めてたんだけど、、、一時間後に先生が検討しよう、というので、そのことを報告したら、間違えたデータとやり途中のデータみたいからどっちも持ってきて、とのこと。 それで一時間後に両方を持って会議をしました。 先生、ちゃんと計算の公式を持ってきてくれて、優しく教えてくれて、、、 何で私が計算で躓いてるってわかってたんだろう!笑全部計算が終わったらまたミーティングをすることになりましたよ。大量にあるので一日ではとてもやり切れず、時間切れ。今日は5時半から予定があるのです。今日の予定は、もう一人の先生に頼まれたロータリークラブの会に出席すること。自分についてのプレゼンを2分お願いします、といわれているものでした。行ってみると、思ったとおりお年寄りがたくさんいましたよ。。趣旨としてはインターナショナルの学生と親睦を図る、ということのようで、10人の学生、それぞれ違う国出身の人たちが、それぞれパートナーを連れて出席してました。(子供はだめだったのでうちは旦那さんはこなかった)対するロータリークラブのメンバーは大量! ひとつのテーブルに、学生が一人とクラブのメンバーが3,4人ついて着席でした。 最初からテーブルは決まってたんだけど、私の席の人は、日本に子供が住んでたんだ!と 凄く日本びいきの人ばかり。この大学の卒業生で今クラブのメンバーの人もいましたよ。いろんな話したけど、その卒業生の人の一人はいろんなことに凄く博識で、それで、放射能はいまどうなってるの?って話になったときに、私が、変わらず出続けてるんですよって言ったら、もう修復は不可能だからね、といったんですよね!そうそう、1万年ですから!って言ったら、しかもそれが半減期だからね、とのこと。 おお、、、詳しいぞ!学内のカフェでのディナーで、料理はビュッフェ形式だったんだけど、 何度も取りに行く感じじゃなくて、一度しか食べられずちょっと残念笑メンバーの会議みたいなのをはさんだ後は、デザートを食べて、自己紹介に。どの人もプレゼンが上手で、、、彼らがあの大会出てたら勝っただろうななんて思いながらも それぞれの紹介を楽しみました。 二時間ほどで会はお開きになると、歯医者さんのメンバーが君と話したかったんだ!と 来てくれてしばし歯科のことおしゃべりしたり、日本に子供がいってたんだよ!とまた別の人に話しかけられたり、、、いろんな人と話した二時間でした(^^ 買い物して帰ると、私が帰ってから食べる!と皆待っていたそうで、、、もう8時半なのに今頃ご飯を食べていました。。。美味しそうな豚肉の入ったポトフでしたよ。 ブログランキングに登録してみました。 よかったらポチっとしてみてください(^^ ↓ にほんブログ村
2014年06月27日
コメント(2)

23日今日は朝出かけようと思ったらぶどうくんが頭が痛いと言い出し、、、でも幼稚園は行く、というので連れて行ったら、到着したらもっと頭が痛くなってきた、とのこと。じゃあ今日は休むか、とつれて帰って私は大学へ。大学内のオーガニックの畑に野菜を取りにいった後は、今日は政府の検査の日なのでラボは使えないからパソコン仕事。データを入れて、後はプレゼンの準備して。。。あっという間に一日が終わり急いで家へ。旦那さんと交代して、みかんをアートに送り出しりんごのお迎えへ。迎えにいくとりんごの先生が、明日から新時間をはじめたい、とのこと!えー、もう6時半終わりスタート!?でも確かに、今月末と来月半ばの大会に向けて練習したいんだろうね。。。りんごを連れ帰って皆が帰宅してから夕食は、今日はリクエストによりカレー。美味しかった♪そういえば、ダンスどうなった!?って双子に聞いたところ、、、なんとびっくりの結末に。。。親友のYちゃんと、もう一人の親友Aちゃんが、どっちも妖精がやりたいと言い出し、、、それ見て、ダンスを作ってたアニーに出演したMちゃんがいやな気持ちになって、、、空中分解したんだそうな笑。子供らしいというかなんと言うか笑で、今日はぶどうくん、幼稚園休んで超得しちゃったみたいなんだけど、しまじろうが来たんですよね!笑待ちに待ってた、動物の鳴き声の機械が来たので、それはそれは嬉しそうでしたよ。それで、習い事がちょっと変化するのはりんごだけじゃなくて、実はみかんもなんです。前学期にもう一人のゆっきいさんのところがアートをやめてしまったんだけど、今学期で台湾の二人もやめる、とのこと。私は全然内容にタッチしてなかったから知らないんだけど、やめたどちらも同じこといってたんだけど最初はよかったんだけど、技法は途中から新しいことがなくなって、進歩がなくなった、つまらない、んだそう。みかんに聞くと、自分は楽しんでた、んだそうだし、AさんとこのEちゃんも楽しく通ってたのでそれじゃあ来期、皆が抜けてしまっても誰かと合同にしてもらって一緒に続けようか、って言ってたんですよね。でも先日、ふとバレエのクラスのことが気になって、もう一度クラスわけの紙を見てみたら、自分のレベルのクラスなら何クラスでも取れます、とかいてあるのを発見!先日の発表会で、みかんが行ってる土曜日のクラスは、初心者から中級の下のクラス+中級クラスのダブルだ、ということをやっと知ったんですが(半年やってたのに遅すぎ!?笑)、どうもその最初のクラスはみかんには簡単すぎるみたいな気がして。みかんに聞くと、基本をしっかり学べるから無駄ではない、とのことなんだけど、、、どうせお金払うならレベルにあったクラスのほうがいいじゃない?それでもう一度タイムテーブルを見てみたら、どうやら月曜日にみかんのレベルのクラスがある感じなんですよね。で、早速先生に問い合わせメールしたら、、、返事はなかったんだけど、来期からみかんが月曜にもくるわって先生がクラスで言ってたそうで笑。。。結局アートはやめて、土曜の朝一番のバレエクラスもやめて、月曜のバレエに変更することにしました。アート、もうちょっといいクラスがあるとよかったんだけどなあ。。。ブログランキングに登録してみました。 よかったらポチっとしてみてください(^^ ↓ にほんブログ村
2014年06月26日
コメント(2)

6月21日土曜日 今日はみかんをバレエに連れて行ってその足で大学へ。10時半にCちゃんと約束したのでその前に自分の分の用意をして、二人で実験開始。無事12時に終了。私のほうの分は4時間培養しないといけないので、ランチにいって、その後パソコンをしてやっと2時半になったので実験第二弾開始!昨日の分のカウントもしてやっと3時半に終わりました。買い物して帰宅すると、子供たちはどうやらバレエが終わって帰ってきてからずっとビデオ見てたらしい。。。もう夕食なので夕食準備。今日は実験であまった野菜が大量にあるので、野菜尽くしの食卓に。キャベツときゅうりと赤しその漬物、青梗菜と牛ひき肉の炒め物、わかめと千切りにんじんの温サラダ残ってたサラミ、 たっぷり野菜のポタージュスープ。相変わらずぶどう君はポタージュ以外は野菜一切拒否だけど、双子は最近すごくベジタリアンっぽくなってきて(特にみかん。りんごは肉がないとご飯が食べられない)、野菜を大喜びしてくれるようになったのでよかったなあ、と思います。私もピーマンとかなすがこよなく好きになったのって3年生ぐらいだった、と思うので、そのくらいに好きになるかなあ?って思ってたけど、ばっちり!でした。そういえば、進研ゼミ、三ヶ月に一度赤ペン先生があって、手書きでテストみたいに添削を出さないといけないんですよね。毎日楽しくパッドはやってるけど、赤ペン先生出さないと!ということになり、やらせてみたら、、、2,3分して二人とも体中がかゆくなってきて、、、笑、補習校の宿題、再来といった感じ笑何であんなに嫌なんだろ。。結局今日はやめよう、と放り投げてしまいましたよ(^^;夜は久々に義母と電話したり、うちの両親とすかいぷ。気がついたら半年以上してなかったもんなあ。22日 今日は朝から何度も邪魔されつつ9時半までがんばって寝て、、、起きた後は子供たちは子供たちで遊んでたので私も久々にパソコンをして過ごしました。お昼ごはんには旦那さんがチャーハンを作ってくれて、ごろごろのんびりすごし、3時半ごろからやっと始動。まずは買い物へいって、その後大学へ。一時間ほどかかってパソコンのところへ戻ってきたら、子供たち、志村けんの馬鹿殿見てました(^^;帰宅後はリクエストによりしゃぶしゃぶ。二日間で相当量野菜を消費しましたよ笑そうそう、昨日スカイプ中に家に人が何人かやってきて、犬が迷い込んだみたい、、、というのでどうぞ探していいですよって言ったんですよね。旦那さんが一緒についていったんだけど、、、どうやら、その犬、その探していた人の犬じゃないらしい!前にもリードなしで我が家の庭で遊んでたりした大型犬で、、、今日はかなり鳴いて興奮してあちこち走り回って、我が家の裏庭に迷い込んだんだって。飼い主はたぶん近所の中国人で、今いないんだそうで、、、で、危ないから捕まえようって話になって、近所の数件でみなで追いかけてたんだって!そうなんだ!そこでみなで捕まえないと危ないってなるところが、やさしいなあ、ありがたいなあ。探していいですよ、なんていっちゃって悪かったなあ!無事捕まえてつないでおいたらしいけど、、、あの犬よく歩き回ってるから、普段つないでないのかな・・・?飼い主が見当たらないって、食事はどうしてるんだろ。。。大型犬に子供がやられる事件が多発してるだけに気になります。。。ブログランキングに登録してみました。 よかったらポチっとしてみてください(^^ ↓ にほんブログ村
2014年06月25日
コメント(0)

6月20日 今日はぶどう君を幼稚園に送ったときに、とうとうお誕生会の招待状を渡すことに。 ぶどうくんによれば、いつもここの棚に招待状が置いてあるんだ、というので、もしかして先生が渡してくれるのかな?と思って幼稚園で聞くと、やっぱり、お友達の親に渡してくれるらしい。 預けてきました。その後大学へ。 来週、政府の機関が、実験室の安全性をチェックに来る、ということで、今日は総出でラボの掃除から一日がスタート。 昨日わかった件を相談してからでないと次の実験ができないので、掃除が終わってすぐ先生を捕まえて相談すると、やっぱり昨日私が思ったとおりの結果でした。 でも、あとでちゃんとミーティングしよう、とのことで、お茶タイムが終わったら呼ぶから、といわれて 待ってたんだけど、、、ランチタイムを過ぎて、、、、もさっぱり呼ばれず。今日は仲間のプレゼンだからなあ。無理だろうなあ、と一緒にやってるCちゃんと話し合い、明日、土曜日にやるか、とラボの鍵を借りてきましたよ。。。データも終わったし、それじゃあプレゼンの準備でも、とプレゼンのトークを考え、スライドを手直しし3:20になったので仲間のプレゼンへ。 プレゼンは、同じ学部だけど違う部署の人たちもきていて、、、その人たちの質問が厳しかったなあ。まず質問の英語が厳しい! 日本の学会で発表したときにも答えられるか怖かったけど、そこにさらに質問の意味がわかるか、という怖さまでついてくるということがわかりました(^^; プレゼン後はちょっとだけラボで働いて、りんごのお迎えへ。 そうそう、ジムの大会シーズン後の予定というか日程が発表になったんですよね。 週に二度4時から6時半、週に二度4時から6時プラスバレエ一時間。今まで週4で6時間だったのが、11時間になる! バレエはバレエの先生に来てもらうんだそうで、バレエもやりたかったりんごはうれしそうなんですけどね。親としては、値段がわからないので、時間が倍になっちゃうといくらになるんだろう、、、って そんな話で持ちきりでした笑 お迎え時間的にはいつも一生懸命5時に帰ってたのが6時半まで大学にいられるのでありがたいんですけどね。帰宅後、今日はくっくぱどのメールで見たレシピがおいしそうだったのでそれを作ってたんだけど http://cookpad.com/recipe/861203いつもすごく早く帰ってくるだんなさんと二人が、プールからいつまでたっても帰ってこないんですよね。私は心配性なので、三人でトラックにつぶされたんじゃないか、とか、 二人のうちのどっちかがおぼれて人工呼吸中なんじゃないか、とか嫌な予想ばっかりしちゃってたんだけど、、、 しばらくしたらりんごがキッチンにやってきて、遅すぎる、、、おぼれたんじゃないかって言い出して、、、やっぱりりんごって、私や母、祖母の心配性の血を一番継いでるんだよね笑 で、りんごが携帯に電話してみたけど出なくて、、、嫌な予感は膨らむばかり、、。探しにいこうよ、とりんごが何度もいうので、そうしようっか、と二人で沈黙しながら車を走らせました。途中トラックにつぶされた車もないまま笑、走らせて、もう少しでプールに着くというところで、、、 いた!対向車線に!よかったーー!!! ということでUターン。すっかり明るくなった車内の空気。私はりんごと二人だけでどうやって 生きていったらいいかとか考えちゃったよー、といえば、三人とも死んでるところ考えて 頭の中でわー!って叫んでた、とりんごがいい、、、笑、うん、それママもよくやる!と笑いながら家に帰りましたよ。 夕食の豚肉はすごくおいしくて、大量野菜のスープもおいしくてあっという間に完食でした。 ブログランキングに登録してみました。 よかったらポチっとしてみてください(^^ ↓ にほんブログ村
2014年06月24日
コメント(2)

6月19日 今日は朝畑で野菜をもらってきて実験の準備をして、11時から久々にミーティング。 仲間が明日、リサーチのプレゼンをするそうで、その練習も兼ねてでした。 毎日のように誰かのリサーチプレゼンのお知らせが入ってくるけど、人のまで聞く時間はない、と 聞いたことなくて、、、でも来月には私もしないといけないのよね。。。 一度上手そうな人を聞きにいかなくては、と思ったのでした。 お昼後はオーガニックの畑に野菜を取りに行った後、あまり時間がないので、 朝の野菜だけ実験することに。 それを終わらせて、まとめたデータを先生に送って、今日はりんごが迎えにいけるぞ とパソコンをしていたら、この一週間やったサルモネラとO157のデータの読みかたって ほんとに合ってるのかな?とふと不安になり、再度詳しく調べ始めたら、、、色々と問題点が発覚。 つい夢中になって、りんごのお迎えにすごく遅れちゃった。。。 迎えにいって買い物する間もずっと考えてたらだんだん煮詰まってきたので、 だんなさんに相談したら頭がまとまってきて、、、方向性が見えてきた♪ やっぱり人に話すって大事だよねー。 夕食は頭がいっぱいだったので、買ってきたローストポークと、ベーコンとキャベツ炒めと青菜のみ、という 寂しい食卓になりました(^^; 食後はまた絵本を読み、子供たちを寝かしつけ私は、早速日本語であれこれ検索して調べてみましたよ。 いやあ、日本語のサイトって、親切だよね。。 詳しい科学の実験のやり方とかが一般のQ&Aとかに載ってたりするんだもの。 で、読みふけったら、今まで知らなかったことがいっぱいわかって、、、納得! 安心したのでした。 そうそう、双子の話なんだけど、ダンスでテレビに出たり、アニーに出たりしていたクラスメートが アニーの上演が終わって帰ってきて、仲良くしてるらしいんですよね。 で、彼女が考えた話とダンスで、仲良しばかり集まって、ストーリーのあるダンスを練習してるらしい。 別にどこで発表するわけでもなく、単なる遊び、なんだそうだけど、面白い遊びだよねえ。 うまく出来上がったら集会で発表しちゃえばいいじゃんっていっておきました。笑 それから今日はみかんが、掛け算のバトルをクラスでやったときに、みかんよりも二つ上のレベルの 算数のクラスにいるクラスメート(みかんのひとつ上がりんごのレベル)に勝ったんだって! たまたま知ってる掛け算が続いたからって、みかんはいってたけど、みんな、あの子に勝つなんて!と おお!となったらしい。チャレンジパッドのおかげかな? みかんはとてもうれしそうで、よかったです。 ブログランキングに登録してみました。 よかったらポチっとしてみてください(^^ ↓ にほんブログ村
2014年06月23日
コメント(2)

6月18日 今日もいつものようにぶどう君を送って大学へ。 午前中はデータと格闘してあっという間にお昼になり、午後は細菌をカウントしてちょっと実験したらもう帰る時間! 帰宅して旦那さんと交代。今日はいつものメンバープラス、もう一人のゆっきいさんところの長女ちゃんもいて 楽しそうでしたよ。 夕食は久々にシチューに。おいしかった。 夜はみんなであやとりをしたあと、たまには絵本を読んであげなきゃ、と、母から送ってきた 日本の昔話全集を半分以上読みました。 そしたら、中に天照大神の話があって、、、双子が興味をもったんですよね。 これは!!!と以前から買ってあったけど読もうとしてくれなかった日本の神話を読み聞かせ始めました。 国つくりの話が終わって、ヤマタノオロチの話を、これ、出雲の話だよ、といって話し始めると、 あ、知ってる、 それでおろちが酔っ払って一つ一つ頭を切られるんだよね!と事細かに内容を 知っていてびっくり! なんと、双子は島根にいた一年間何度か見た神楽を、きちんと理解して覚えていたようで、、、 ああ、そうか、神楽って毎回毎回同じのやって面白いのかなあ、とか実は結構不遜なことを思ってたんだけど こうやって日本の、その土地の神話を代々受け継いでいくためのものなのかあ、と偉く感動しました。 私なんて神楽全部見てないし、神話もあまりよんだことなくて、実はヤマタノオロチの話 しっかりと覚えてなかったもの。ああ、島根にいた一年間、いい経験だったんだなあ、と 改めて思いましたよ。 (そして、私は天照大神の話をよく視覚的に覚えてるなあ、と思ってたんだけど、 やっぱり九州一人旅のときに高千穂で神楽を見たんだった、ということを思い出しましたよ。) そして次の話は因幡の白兎の話で、、、これも、因幡にいったよね!なんて話しながら読み始めたら 今度はこちらは教科書に載っていたんだそうで、こちらも詳しく話を覚えていました。 うれしいな、外国にいるのに日本の神話をちゃんと覚えていてくれるなんて。 補修校にも感謝ですね。 ところで、我が家はセロリは私しか食べないのですが、セットで買っている野菜にセロリが続いて セロリがたまってたんですよね。 きんぴらにするのは好きなんだけど、一人で全部食べるのはきついなあ、と思ってて そもそも調理すると、くさいくさいとしばらく皆がうるさいので、何かレシピないかなあ、 と検索したところ、漬物発見! http://cookpad.com/recipe/1336753 これ、めちゃくちゃ美味しかった! 口が凄くくさくなるのが難点だけども笑、あっという間に大きなふた束の茎をぽりぽりぽりぽり 消費しちゃいます。お勧め! ブログランキングに登録してみました。 よかったらポチっとしてみてください(^^ ↓ にほんブログ村
2014年06月22日
コメント(0)

6月17日 今日は特に大きな出来事はないのでちょっとのんびり。朝からデータと格闘し、お昼ご飯後も格闘を続けて、昨日の実験の数を数え、大量のプレートを作って一日終了。りんごを迎えにいって買い物して帰宅し、夕食作り。今日はステーキに。それと青菜をゆでて、紅白なますを作って、たまねぎと、ゆでたにんにくの茎はステーキを焼いた後に炒めて。。 みかんを迎えにいって夕食後は、もうぶどうくんが眠い、んだそうで。。。 あっという間に寝る時間に。 子供たち寝かしつけた後は久々に夜のパソコンタイム。久しぶりに歯科関係のライティング依頼があったのでね。ところでまた新聞ネタなんですが、そういえばかいてなかったなあ、と思って。クライストチャーチにはまだまだたくさん問題点があるんだけど、そのひとつがお金。 市が、地震で壊れた建物を保障することにしちゃったから(保険会社を守るためだと思うんだけど)とにかくお金がないようで。。。 最初の地震の分だけで予算が全部なくなっちゃったらしいんですよね。 その結果、EQCはひどく値切るし、地価を異常に上げて、固定資産税の税収を急速にアップしちゃったし。クライストチャーチで行われていた人気イベント、フラワーショーや大道芸ショーは 赤字にならないから、と取りやめに。 その上、アスベストがあちこちで使われていたので、シティーセンターのアスベストは濃度が高い。 個人宅でもアスベストがある家があるようで(うちはなかったんだけど)、解体時に 重装備でワーカーがやってくるそうで、そういうときに近隣に一切お知らせがない、とおおもめ。ワーカーのアスベストの健康被害に対する保障もまだまだみたいだし、地震で使えない場所が増えてしまったから大丈夫だった地域(我が家の周り)の家不足でオークランドよりも賃料が高いバブル状態。地震のせいだと思うんだけど、地震の被害がひどかった地域は、雨が降るたびに大洪水。地震とは関係なく、調査の結果、町中の家の庭から、汚染土壌が発見されて、水銀とかなんだけど、(これも我が家は大丈夫だったけど)、その可能性のある人は 調査したほうがいいけど、調査代5000ドルも、土の入れ替え台も全部自分持ち、とか。 我が家は、、、ありがたいことに、どれもこれもその大変なところから免れてるんだけど (ひとつ気になるのは、ぶどうくんの前の幼稚園の隣で大きなビルを解体していたときの、 アスベストなんだけどね。。。)、うーん、正直、クライストチャーチからだんだん人が出て行ってしまうのは しょうがないかもしれないなあ、、、なんて思ったりもしますね。 そもそも地震後、建築関係以外は仕事がないしね。復興する都市って、こういう大変なことがいろいろあるものなんだなあ、といまさらにして知ったような気持ちです。 ブログランキングに登録してみました。 よかったらポチっとしてみてください(^^ ↓ にほんブログ村
2014年06月21日
コメント(0)

6月16日 今日はフレンチなのでばたばたと双子が出かけていき、ぶどう君を送って大学へ。約束していた最後のファームへ野菜を採りにいきました。大学内にあるオーガニックファーム、と聞いていたけど、おお、こんなところに大きなオーガニックファームがあったんだ!しかも有機農業のカレッジもありましたよ!二年間(1年でもいいらしい)で有機農業を学ぶプログラムなんだって。野菜をいただいて大学へ行った後は、プレートを準備して、午前中はデータと格闘。お昼ごはん後早速実験開始。今日はいつもの月曜とは違うので、5時に出ればよくて、必要な寒天を大量に作り終わったらちょうど5時。まっすぐ 例の、学会の役員ミーティングに向かいました。今日の会場は、というか役員ミーティングはいつも、仲良しのキウイの子が働いている会社なんだそうで凄く小さな会社でちょっとびっくり。りんごのジムのすぐそばでまたびっくりミーティングは、来月行われる学会の話で持ちきりで、、、私は全く役に立たないなあ、、、と思いつついたんですが、最後になって、9月に行われる学生イベントを私のスーパーバイザーが担当するので、それをユキにも一緒にやってほしいんだ、といわれました。よかったー。なんか何も出来ないんじゃないかって心配してたけど、それなら私にも出来そう!一時間ほどでミーティングが終わり、次は来月。友達がよかったらラボを見ていって、というのでもちろん、大喜びでラボへ。なんと従業員は12人、フードサイエンティストは三人、しかいないんだそうで、三つほどのプロジェクトを一人でやってるそうで、いいなあ、面白そうだなあ、一日中ああいうことやってるのかあ、という感じでしたよ。おしゃべりしつつ見せてもらって、もう会社をしめる、ということであわただしくお別れ。その後はまっすぐAさんのお宅へ。今日は、旦那さん英語学校だし、私は迎えに行けないので、3人ともAさんにお願いしてしまったのです!みかんのアートの送り迎え、りんごはジムに行ってそこで一時間待っててよって言ったけどいやだといわれたので今日はお休みして、ぶどうくんと一緒にAさんちでお留守番。4時に旦那さんが連れて行ったんだけど、、、なんとそこからみんなでポトフを作ったんだそうで!7時に迎えにいったらみんな夜ご飯を食べていました!私の分もあるよー、とのことで、、、なんとありがたい!!(涙)ありがたくいただいてきましたよ。その後子供たちは楽しく遊んで8時においとまし、帰宅すると旦那さんも帰宅。かわいそうな旦那さんの夕食はラーメンに笑そうそう、ところで誕生日で誰を呼ぶか、というのを考えているときに知ったんだけど、、、双子が仲良くしてる子の内の一人が最近パーティーをしたらしいんですが、、、「りんごとみかんを呼びたかったんだけど、お母さんが、アレルギーだから難しいからだめっていったからよべなかったの」といわれたんだそう。本人たちは、それじゃしょうがないねってすんなり受け取ったらしいけど、私としては、それは残念な話だなあ、、、とちょっとがっかり。だって、連絡先もらえれば、全部食べ物用意しますので心配しなくていいですってメールがおくれたのに。もちろん、あちらの気持ちはよくわかるので、全然しょうがないんだけど、なんだかちょっと、とても残念だったなあ、と思っちゃったのでした。ま、そういうこともあるよね、と思うけど。前にも、私の親戚に、あそこのうちは呼ぶと食べ物が面倒だから今回は呼ばない方向でとか言われちゃったからね。うん、しょうがないんだけど。ブログランキングに登録してみました。 よかったらポチっとしてみてください(^^ ↓ にほんブログ村
2014年06月20日
コメント(2)

6月14日 今日はバレエのお見送りぎりぎりまで寝てバレエへ送り、その後皆で買い物。 ぶどうくんのお誕生日会を今計画中で、それが近いのでいろいろ買ってきました。 帰宅後はお昼ご飯にキャベツ大量消費ということでお好み焼きを用意して、またみかんのお迎えへ。 帰宅後皆でお好み焼きを食べた後は皆で大掃除。二週間ほど異常に忙しくてひどい状態だったので 皆で手分けして片づけをして、掃除をしました。 旦那さんはやっと元気になってきたので卓球へ。 (多分運動しないからかぜ引くんだ、とかぶつぶついいながら笑) あちこち大掃除してやっときれいになり、ちょっと一休みして4時から皆で大学へ。 一時間ほど実験をして、その間いつものように子供たちはパソコンゲームやアイパッドで遊び、 買い物して帰宅。夕食は、寒いからポトフにしちゃおう!ということに。 あれ以来腰が凄く弱くなっちゃって、すぐに痛くなるので、ベッドで横になることが多くて、、、 そのまま子供たちと一緒に寝てしまう日々が続いています。。。 6月15日 今日は何もないひだから、と10時過ぎまで寝かせてもらい、始動・ まずは昨日買ってきたきれいな紙に、双子の誕生日会のほうのカードを印刷。 そして双子の誕生日会とぶどうくんのぶんと、招待文を書き込みました。 今年の誕生日会、プランではこんな感じ。 ぶどうくんー悩みに悩んだ末、ぶどうくんがどうしても家でしたいというのでがんばることに。 目玉は大きなテントで風船遊び笑とトランポリン。 パーティー会場借りるよりは安かったけど、いろいろ必要なものそろえるのにも結構お金がかかりました。。。 呼ぶのは8人ぐらいらしい。日本人は呼ばない、とのことで、全員外人さんです。 パーティーの食べ物、お土産、ケーキの用意も準備しましたよ。 双子ーこちらも悩みに悩んだ末、今回は、ものすごい面白いスポーツの場所へ。 子供5人につき大人一人必要なので、うちの夫婦、Aさん、台湾のママで4人ならすぐに頼める、ということで 20人までと限定。 早速20人で会場も予約しました。カードはこちらをプリントアウトして、というのがあったのでそれを プリントしたんです。こちらは、食べ物とケーキ、持ち帰りのお土産だけ用意すればいいので簡単なはず。 準備が終わった後は、今日は双子が、編み物をやってみたいというので編み物ですごしました。 二歳ぐらいのころから何度も教えては挫折してきた棒編みの編み物、、、8歳にしてとうとう出来るように! 結構編み物って難しいんですね。 今日も4時から大学へ行ってカウントして買い物して帰宅後は 夕食は、キャベツ消費で回鍋肉と味噌汁にしたんだけど、どっちもちょっと味噌がきつすぎて、、、 反応はいまいちでした、残念。。。 ブログランキングに登録してみました。 よかったらポチっとしてみてください(^^ ↓ にほんブログ村
2014年06月19日
コメント(0)

6月12日 昨日夕方に、もうひとつの畑へメールしたところ、明日の朝なら大丈夫、といわれたので 今日はぶどう君をおくった後はまっすぐその畑へ。 野菜をいただくため、広大な畑を回りながらいろんなお話を聞きました。 こっちのスーパー(CD社)って、微生物を減らすために、塩素を使うんじゃなくて、(におうから、とのこと) 三回洗って、そのつどスピンドライで乾かしてるんだって!なんて素敵な試みかしら! 日本も簡単に薬剤使わず、そういうことしてくれればいいのに! 野菜をいただいた後は大学へ行き、プレートに名前をつけて準備して、 中国人の彼女と一緒に実験準備。 お昼を食べて、いつものオーガニックファームへ野菜を採りにいき、 また今日も飲まず食わずで実験。。。 一緒のことが終わった後は一人でやらないといけないことが多量にあって、、、終わったら6時半でした。。。その後メールの返信だけして(最近家に帰って子供たち寝かしつけるともうパソコンに戻れないんですよね。。。)、帰宅すると皆がまだ起きていて大騒ぎ。夕食はパスタを作ってもらったらしく、もうなかったので、私は今日もラーメンに(^^;そうそう、今日メールで頼まれたんですが、なんと!プレゼンのファイナルに残ったうちの4人で学部の一年生向けにスピーチをしてほしいって!しかもこの間と同じにしてくれればいいのに、5分だとか。。。 しかも、コミュニケーションスキルの授業らしいですよ! ネイティブに向かって、そんなことできるのかしら。。。何より忙しいなあ。。。 あ、そうそう、りんごが言ってたんだけど、最近真剣に悩んでるんだそうな。 Lくんと、Hくんと、どっちがすきなのか笑。 どっちもりんごのことが大好きなんだそうなんだけど、、、きいてみたら、その二人はみかんも好きなんだって。っていうかりんごとみかんを判別も出来ないことがあるらしい。つまりその二人はこの双子の顔ならどっちでもいいってことでしょう?笑そんな人たちがすきなんてちょっとおかしいよね笑りんごだから好きって言ってくれる人好きになればいいのに、、、まだ3年生じゃわからないかな(^^; 6月13日 今日は朝からもうひとつのファームに電話したところ(昨日も5,6回したけど通じなかった) やっと通じて、来週の月曜に約束が出来たので一安心。 午前中はデータを処理してあっという間に終わり、午後はプレートを作った後、細菌のカウントして昨日の実験の続きをしないやつを終わらせたらもう帰る時間でした。今日の結果で、、、サルモネラもO157もばっちりいたもんだから、先生も、これからはこの部屋は二人以外立ち入り禁止にする、しっかり除菌して帰るようにって言ってました。 いやあ、生野菜にあんなにたくさんいると怖くなるね。。。 そうそう、いつものようにお昼に新聞を読んでますが、凄いニュースがあったんですよね! 最近雨が降り続いてたので、またもやクライストチャーチではひどい洪水が起こってたんですが、12歳の女の子が洪水に流されておぼれかかってるところを若い男の子が助けたというニュース! 最初はおぼれてなくて、深みにはまってて、大丈夫!?と声をかけていたら、流され始めたそうで、、、えらいのはすぐに水に入らないで、入る準備をしつつ、第三者を探したんだそう。 一人見つけたので、僕にも何かあったら即通報してくれ、と頼んですぐに水に入り、 女の子の背後から抱き上げて水面の上に顔があがるようにして、岸にたどり着いたんだとか!よくニュースで、助けようとしておぼれた人の話、どうすればよかったのか、という話は見るけれどそれを全部実践して助けた男の子は凄い!と思って。二人とも病院へ運ばれたけど、すぐに回復して、女の子の親が駆けつけたときには、 女の子は、病室でおぼれたときに背負っていたリュック(!)に入っていたランチを食べてたんだって! いやあ、すごい、と感動してうちで皆に話したんだけど、双子も案外、そういうやり方を知ってるので またびっくり。 水泳の時間に、洋服を着てボートから落とされる授業をした(笑)、というのは聞いてたんだけど、 いいこと教わってるな!って思いましたよ。 で、日常に戻って、、、りんごを迎えにいって買い物して帰るとみなもうプールから帰ってきたので急いでご飯作り。今日は元気があったので、揚げ物油を無駄にしないように、かぼちゃコロッケを作りました。 あ、そうそう、昨日書き忘れた、というか先週も書き忘れた!? 歯医者さん登録にいきましたよね、先週。そこでなんと!りんごに虫歯が!!!! 歯が生えてからずーっと親が磨いてたのに何たる失態。。。しかもりんごは甘いもの嫌いで食べないのに。。。 最近ちょっと面倒で適当に磨いてたのよね。。。 でも乳歯だったのでまだよかった、、、。 ということで木曜日に予約を入れてりんごは治療をしてきたんです。 麻酔したんだそうで、ちゃんと麻酔ゼリーも塗ってもらったみたいで、全く痛くなかったんだって。 全然怖くなかったって笑ってましたよ。 ブログランキングに登録してみました。 よかったらポチっとしてみてください(^^ ↓ にほんブログ村
2014年06月18日
コメント(0)

6月11日今日はとうとうプレゼンの日!本当は旦那さんが語学学校だから、3時ごろに大学に子供たち連れてきてもらって、プレゼン終わったら私と一緒に帰ろう、なんていってたんだけど、今日も旦那さんはとてもじゃないけど、大学と語学学校まで運転できそうにない、とのことで、こないことに。大学へ行った後は、まずは残ったプレートを作ったり、昨日の細菌を数えたり。お昼後に会合があって、それが案外長くてやきもきしつつ、終わった後は一人で外で練習。。。そして本番に!この数日の練習で、メリハリをつけたり、身振り手振りを大げさにしたり、ちょっとしゃべる以外の余裕が出てきた感じで、前回よりもだいぶパワーアップできたな!という感じ。今回はさらに大きなホール。私は8人中7番目の順番でした。二番目は、私が一位だったときに2位だった人。この人、多分レクチャーとかをしたことがあるんじゃないかっていう感じのすっごくベテランな人で、ただ、ベテランなだけあって、多分はきはきさが足りなくて前回は2位だったんじゃないかって思うんだけど、多分指摘されたのか、、、今回はものすごくはきはきしてよくなっていて!うわあ、こりゃあ、この人も優勝候補だな、ってびっくり。その後の人は余りよくなくて、一番の優勝候補の中国人の男性が5番目に登場。うん、やっぱり凄くいい、ダントツにいい。その次の人は、前回凄くよくて、2位予想をしていたんだけど、ふたを開けてみたらあまりよくなくて、、、そして私の番に。私は、、、今回はかなり緊張して、声が震えてたし、練習ほどには余裕を持ってしゃべれなかったんだけどでも凄くよく出来たと思う!印象的だったのは、しゃべってるときに何人かの人が、うんうん、ってうなづきながら内容を聞いていてくれたこと!そしてあっという間に最後の人も終わりました。審査は難航し、、、予定よりもずっと長引いてやっと審査員が入ってきて、、、1位と2位の発表!なんと3位以下は発表しないらしい!えー!3位を狙ってたのに!笑二位は、その、前回私に負けた、ベテランの人でした!そして1位はもちろん中国人男性。優勝のコメントも、爆笑を起こすコメントで、、、さすが違うわ、、、という感じでしたよ!終わった後は懇親会があるのでぜひどうぞ、といわれて懇親会のほうへ行くと、ジャッジをはじめいろんな人に、ほんとに上手だったよ!と凄くほめられました♪ラボの先生は去年出たそうなんだけど、(去年まで博士号の学生だった)、感動したよ!本当に上手だった!と大絶賛(^^今回は強敵だったけど、去年だったら賞もらえてたよ!とまで言われましたよ!そして前向きな私としては、、、もしかして、、、、審査に難航してたし、、、私は僅差の3位だった!?と思ってマス笑美味しく懇親会のものを食べてたんだけど、中国人の一緒に研究してる子に、そろそろ私たち戻って実験の続きしたほうがいいじゃない、といわれて、実験へ戻り、、、今日はそんなわけで子供たち迎えにいく必要もなくなったので、プレートを大量に用意したりして、遅くまで実験をして帰ったのでした。帰ったらまだみんなおきていて、夜ご飯はチャーハンを食べたんだって。中国人の彼女が動画をとってくれたので、それをみんなに見せたりしましたよ。緊張したけど、楽しい充実した一日となりました。ブログランキングに登録してみました。 よかったらポチっとしてみてください(^^ ↓ にほんブログ村
2014年06月17日
コメント(2)

6月10日 今日はぶどうくん遠足の日!雨だから長靴と雨合羽を忘れないようにね!といわれてたので、普段は自分で洋服着られないーとか言うくせに、今日は凄い早いうちから全部用意して笑玄関で待機してました笑幼稚園に連れていったあとは、大学へ。まずは昨日作った培地をプレートについで、早速実験開始!今日は例の中国人の彼女も一緒にやるように、とのことで、一緒にやりました。とうとう今回はすべての微生物の準備がそろった最初の日。量の多いことといったら。。。お昼ごはんをはさんで、結局終わったのは6時ごろでしたよ。。。実験室は食べ物禁止だからお昼以外は飲まず食わずだし、、、疲れる。。。。一緒にやることが終わった後は、私が用意しないといけないものを一人で用意して、ちょっとパソコンで大事なメールだけ返してなんとかみかんのお迎えに間に合った!みかんを連れて帰宅後、夕食は疲れちゃったし、旦那さんは具合が悪くて食べたくない、というのでまたラーメンに(^^;で、ぶどうくんの遠足は、それはそれは楽しかったみたい(^^遠足の何が楽しみかって、公共のバスで移動することらしいんですよね笑幼稚園の前からバスに乗って、途中で乗り換えてまた乗ったんだって!博物館で、Bodyの勉強した?って聞いたら、うん、それは見ただけ、とあっさりだったけど笑一生懸命はなしてくれたのは、どうやら博物館にいろいろ仕掛けがあったんだそうで、それが面白かったみたい。それとアザラシが固まってたんだよ!って。人も一人固まってたけどね。。。死んだ人かな?とか言ってましたよ笑疲れたようで、帰った後グーグー寝ちゃったらしく、、、11時まで寝てくれなくて!おかげで、私は結構眠くなかったのに、今日もパソコンは触れずじまいでした。。。あ、そうそう、その後ぶどう君の小学校準備なんですが、英語の先生から連絡があったんですよね。クラス編成がちょうど入った一ヵ月後に変わる事になってて、ぶどうくんはシャイだから、クラスが途中で変わっちゃうよりも、クラスを編成した後に入ってきたほうが慣れやすいんじゃないかって。ぶどうくんがシャイって、、、よくわかってるなあ。確かに何度か双子の弟として会ったことはあるけど、そこまで理解してくれて、考えてくれるなんてありがたいなあ!!!って思いましたよ。ぶどうくんはなんていうかな?前の幼稚園で友達だったしゅかーれっちゅと遊びたいからすぐ入るっていうかな?って思ったら、クラスが変わるのはいや、後でいい、とあっさり。そんなわけで、お誕生日の次の月まで小学校入学はお預けになりましたよ。ブログランキングに登録してみました。 よかったらポチっとしてみてください(^^ ↓ にほんブログ村
2014年06月16日
コメント(2)

6月9日 今日は朝はフレンチなのでどたばたと双子は出かけていき、ぶどうくんを 幼稚園に送り大学へ。作らないといけない寒天培地にちょっと問題があったのでその問い合わせなどを 先生としたりしたあとは、金曜の残りの培地をプレートに継ぎ、昨日買った野菜を実験で使うための プレート全部を用意して名前を書いて、特別な寒天培地をつくり、あっという間に夕方に。 旦那さんが具合悪すぎて学校に行けないというのでりんごの迎えに時間に帰ればいいことになり 最後はちょっとのんびりしてりんごのお迎えへ。 待ってるときにお母さんたちのおしゃべりで、面白いことがあったんだけど、 ママA「いつもいつもマオリの歌ばかり教わってきていやよねえ。うちでマオリ語ばっかり聞くことになって。。。 もっと普通の歌も習ってきたらいいのに。。。」 ママB「公立?私立?」 ママA「公立よ」 ママB「それじゃあしょうがないわよねえ。いやだけど、、、政府の方針になっちゃってるから・・」 ママA「そうよねー・・・・」 なんて話してましたよ。 そうなんだ。やっぱり白人のNZ人はイギリスとかの昔ながらの歌を歌わせたいんだな。 マオリに対するスタンスってそんな感じなんだなあ、と新鮮でした。 確かに日本語とマオリを半々でします、とか突然決められて、言葉も歌も半分マオリ 教わってきたら、私たちも文句のひとつも出るかもなあ、なんて思いましたよ。 まあ、マオリが先住民であって、そっちのほうがNZ人の先祖なわけだけどね。。。。 りんごをつれて買い物して帰宅すると、旦那さんはもう、凄い熱でダウンしていて、 急いで夕食作り。 ラーメン食べたいと子供たちが言うので、じゃあたっぷり野菜スープと、ラーメン、という 不思議な組み合わせに笑 ぶどうくんによると、今日昨日のお誕生日の子、幼稚園に恐竜持ってきてたんだって! 気に入ってくれたようで喜んでました(^^ そうそう、そういえば、先日お友達に、辞書引き学習、なるものを教えてもらったんですよね。 好きな言葉を辞書で引いて、そこに付箋を貼っていくらしい。 http://jishobiki.com/ 面白いなあ、と思って二人に話してみたら、乗り気になったんですよね。 ちょうど荷物に、購入した国語辞書が入っていて、二人分辞書がそろったので、 やってみる!と言い出した二人。 それから毎日がんばってる様子。 特にりんごがはまってて、どんどん言葉がわかって面白い!と進めてるみたい。 みかんはそれほどはまってないんだけど、がんばる、とのこと。どうしてかな?って思ったら 「私の家族はみんな勉強が出来るから、私もがんばって勉強が出来るようになりたい」だって! そんなこと思ってたんだー! で、二人とも、学校で、メモのとり方を習ってきたんだそうで、 このサイトで紹介されていた、調べた言葉と何番目の言葉かを書く、だけじゃなくて、 同じ読みで別の漢字があった、とか、同じ言葉でも二つの意味があった、とか、 そんなメモまで残してるんですよね。案外やるなあ! 補習校を辞めてからのほうがいい感じで日本語に触れられている感じがします。 言葉をいっぱい知ってくれるといいな! ブログランキングに登録してみました。 よかったらポチっとしてみてください(^^ ↓ にほんブログ村
2014年06月14日
コメント(2)

6月8日 今日は朝のんびり寝て、朝ごはんを食べた後皆で野菜を買う旅に。サンデーマーケット、八百屋、中華街、スーパーと周り、ついでに我が家の買い物もして帰宅してお昼ごはんは昨日のしゃぶしゃぶで作ったぞうすい♪おいしかった(^^あ、そうそう、旦那さん、最近登場してませんが、2週間ほど前からずーっとおなかを壊してずっと苦しんでる上、おとといくらいから風邪も引いてずーっと寝てる感じ(^^;お昼ごはんの後は用意をして私とぶどうくんは誕生日会へ。今日のパーティーはマクドナルド、だそうで、行ってみると、ちゃんと個室があってかわいらしく飾ってありましたよ。次々集まってくる友達を見ていてわかったのは、、、この仲間は、、「チーム、シャイ」だということ笑みんなぶどうくんみたいにもじもじ君でお話できないの笑で、チームシャイは、ほとんど、白人。旦那さんによると、あの幼稚園アジア人たくさんいるけど(日本人はぶどうくんだけ)、ほかのアジア人はかなーりやんちゃらしい。アレルギーの話したら、用意するわ!って言ってくれたんだけど、ほんとに、レーズンのスコーンと、スパイダーの乗った乳製品不使用のクッキーを作ってくれてました!ありがたい!ほかにも二人アレルギーの子、しかも内容が違う子がいるらしい。ぶどうくんによると、その子はいつも、お誕生日があるとぶどう君と一緒にクッキーを食べるんだって笑ぶどうくんも、ぶどうくんの親友も、一人ではいすに座れない、とママのひざの上に座ってみんながそろうのを待ちました。なかなかやってこないから遊びに行こう、とキッズスペースに移動すると、さすがに普段は幼稚園で仲良く遊んでるだけあって、大騒ぎで遊び始めました(^^でもお誕生日の主役はシャイで遊べずママに抱っこだったけど笑散々遊んで、食べ物が来たよー!ということで席に戻り、ハッピーセットを一人ずつもらいました。ぶどうくんは、バーガーよりチキンナゲットなのでナゲットとポテトとジュースとおもちゃ。もうさすがのぶどうくんでも食べきれないそうで、、、もって帰る、とのことでかばんへ。。。プレゼントをあける時間があって、(恐竜は喜んでもらってましたよ^^)、ケーキカットタイム。ママが作ったというチョコケーキに、こちらの定番、青いアイシングがかけてあって上にはスーパーのP社で買ったというスパイダーマンのシートが乗ってました。ふむふむ、我が家も見に行かなくちゃ。私はケーキいただきましたが甘さちょうどで美味しかった!クッキーも美味しかったですよ。最後はお客さんのパパが、風船で子供たちにサーブしてぶつける遊びをしだし子供たちは大騒ぎ(^^プレゼントをいただいてお開きになりました。もう少しあそこで遊んでいきたい、というので、親友のLくんと二人で楽しく遊び、Lくんのパパが迎えに来たので一緒に帰ることに。帰宅後は夕食作り。今日はリクエストにより、揚げ餃子と、ぶどうくんがずっと食べたいとうるさかったエビフライを作るべく、オーストラリア産のえびを買ってきたのでエビフライ!美味しかった!疲れたようで、夜はさくっと、私も一緒に寝てしまいました。ブログランキングに登録してみました。 よかったらポチっとしてみてください(^^ ↓ にほんブログ村
2014年06月13日
コメント(2)
![]()
6月7日昨日遅かったのに、なんと今日も朝からバレエ!何とか用意して出かけたけど10分くらい遅刻しちゃった。みかんを置いていった後、私たちは買い物。ぶどうくんが明日お誕生日会に呼ばれてるのでプレゼントを買いに行きました。ぶどう君が選んだのは音がなる恐竜のおもちゃ。帰宅後はみんなで母から届いた荷物のうち、漢字のカルタをしてすごしました。ちょうどこの荷物を用意し始めたときは、補習校についていけなくなったときで、あわてて漢字のカルタを三種ほど注文したんですよね。中でもこの、にほんごであそぼ 四字熟語かるた エンスカイは面白かった!した二文字のひらがなと、イメージの絵が描いてあるだけの札なんだけど、そのイメージの絵が面白くて。絵なのでぶどうくんでも出来ちゃうんですよね。まずは四字熟語を全く知らない子達なので、意味を説明しつつ(もちろん紙に書いてある)字で探させてみましたよ。やってみておかしかったのはりんごの事いってる四字熟語が多かった事!馬耳東風、とかね笑。自由自在とか。。。覚えてきたら、四字熟語だけ言って取らせたり、意味だけ言って取らせたりするらしい。そしてもうひとつ子供たちがはまってたのはリンクが見つからないけど。。。。部首でグループ分けされて色がついてるので、部首でウノみたいにしたり、漢字を熟語にしたり、読みをあわせたりと出来るゲーム。まだ熟語にするのは難しいんだけど、部首であわせるのと音であわせるのは出来るので勉強というよりウノみたいに楽しんでる感じ。親としてはこちらのもうひとつのカルタが凄く面白いと思ったんだけど、【楽天ブックスならいつでも送料無料】101漢字カルタ新版 [ 宮下久夫 ]りんご的にはいまいちぴぴっと来なかったらしい。高かったのにな笑そうこうするうちにあっという間にみかんのお迎えの時間に。帰宅後寒いので温かいうどんを作り皆で美味しく食べて、その後また皆でカルタをしましたよ。そしてたくさんプリントしてあるペーパークラフトをしているうちに夜になってしまいました。夕食はみかんのリクエストでしゃぶしゃぶに。今日こそは久しぶりに夜パソコンをしてすごそうと思ったのに、昼間に座ってカルタやらペーパークラフトしたせいで凄く腰が痛くなっちゃって、、、今日もまた早々に寝てしまったのでした。そうそう、寝る前に読んだ絵本、母が数々入れてくれたうちのひとつなんですが凄く面白い絵本!【新品】【2500円以上購入で送料無料】【新品】【本】【2500円以上購入で送料無料】どうやって作るの? パンから電気まで オールドレン・ワトソン/作 竹下文子/訳昔ながらの方法で身の回りのものがどうやって作られるかが描いてあるんです。いかにも西洋風の絵本。届いた日から子供たちのお気に入りです。ブログランキングに登録してみました。 よかったらポチっとしてみてください(^^ ↓ にほんブログ村
2014年06月12日
コメント(0)

6月6日 今日も子供たちを送って私は大学へ行き、午前中はプロポーザルを書き換えたりしてやっと終了し、お昼ご飯後は、ワークショップへ。 3分プレゼンテーションの決勝戦に出る人全員に一人15分ずつアドバイスをいただける、ワークショップなんです。あれから、忘れないように時々つぶやいていたので、ちゃんとトークも全部覚えていて、 大きなホールで先生と二人きりで一度プレゼンをしてみせました。その後発音がおかしいところを二箇所、スライドのおかしいところ、内容のおかしいところ、 などいろいろと指摘してもらいましたよ!それで終わってから急いでスライドとトークを作り直したところ、うん、さらにいい感じになったぞ!そしてその後急いで滅菌が出来上がった大量の培地をプレートに注ぎ、時間なので帰宅。 今日はぶどうくんのプールがあるので4時にうちで待ち合わせ。ぶどうくんとパパがプールに出かけていき、みかんのお化粧と髪の毛を終わらせ、私たちも急いでバレエへ。 みかんたちのクラスのファイナル、お姉さんたちのファイナルが終わった後は、発表会でした。今回の発表会は、今日まで知らなかったんだけど、どうやら、みかんの本当のクラス、中級クラスはないらしく、初級クラスの発表会だったらしい。土曜の一時間目は初級クラスに行ってるのと、木曜の分をお手伝いするので二つだけみかんは参加してました。 なのであっという間に終わってしまって、さらに大きなお姉さんたちのパフォーマンスが 延々と続き、9時近くにやっと最後の結果発表!なんと、みかんたちの優勝は、小さい子でした!でも、確かにその子は一番凄かった子。さすがにトップ3は納得できる結果でしたよ。 長かったバレエの一週間もこれでおしまい。今日はパンやサンドイッチを買って持っていたので、帰宅後は夕食を食べる必要もなく(何が作ってあったかな?忘れちゃった)、また疲れ果てて何もせずに寝てしまったのでした。 そうそう、木曜日に、母から荷物が届いたんですよね!船便なので二ヶ月前に出したと聞いてからずーっと皆で待っていたもの。いつもたくさん洋服が入ってるけど、洋服はたくさんいただけるし、靴が困ってるから今度から洋服じゃなくて靴にして!と頼み、自分でもヤフオクやヒラキでいくつか買い込んでいたので旦那さんは、あけてもあけても靴が出てくるんだけど、、、と不満げ笑 まずほしかったのは双子の学校用の黒い靴で、こっちではローファーって男の子イメージなんですよね。で、日本でよく出てる黒靴だと、あとはフォーマルになっちゃって、でも子供たちはその靴でエクササイズもするんですよ。だからフォーマルはなあ、、とかなり時間をかけて探し回って、、、母が見つけてくれたのがまさにこっちの店で普通に売ってる感じの黒い革靴!こっちでも買ったけど、マジックテープ式しか売ってなくて、マジックテープは一週間で使い物にならなくなっちゃったんですよね。。。 そして、ヤフオクで買ったのはずっとほしがってたおしゃれな黒いロングブーツ。それからヒラキからスニーカー、そしてぶどうくんにはカーズ柄のクロックス風のサンダルと学校用のローファー。そして母がたくさん入れてくれたスリッパ7個笑 ほんとに靴ばっかりでしょ笑で、そのスニーカーを早速学校へ履いていった双子、友達に、その靴どこで買ったの!?って 凄く聞かれたんだって。日本から送ってもらったって言ったら、あー、日本に買いにいきたいー!って言われたらしい笑 ひらきの靴なんて350円くらいで買えるんだから、日本に帰ったときのお土産、スニーカーでも いいね、なんて皆で話しましたよ。 ぶどうくんも、その靴ムービーのだね!クール!って言われたらしいですよ(^^ ブログランキングに登録してみました。 よかったらポチっとしてみてください(^^ ↓ にほんブログ村
2014年06月11日
コメント(2)

6月5日 今日は朝からワークショップ。最終的にきれいな論文を提出するための校正などの方法についてのワークショップでした。すごくためになった!その後、昨日しばらく置いても大丈夫といわれたので早速大量の寒天培地作成。お昼ごはん後は、プロポーザルの見直しをしてあっという間に帰る時間。今日は、4時15分に現地集合。到着するとぶどうくんが、ままが帰ってきたから一緒にいられると思ったようで、、、旦那さんが帰るよというと大泣きで、ひきづられるようにして会場を後にしました笑みかんのお化粧やら髪の毛やらを仕上げたあとは、始まるまでしばらく待ち、今日はみかんたちのグループから始まり。今日はソロで一曲踊りましたよ。うん、なかなかみかん上手だなあ!これならこの予選は勝てる気がする!とうれしくなって、終了しました。その後お姉さんたちのソロが終わり、お友達と一緒に次のプログラムを見ようと思ってたらおなかすいた、おなかすいた、と騒ぐみかん。まっすぐ来たから何も買ってなかったんだけど、みかんたちの勝者の発表までまだ20分くらいあるから、急いで食パンを買ってきてあげよう、と会場を後にして車に乗り込みました。方向音痴だから、地図見て探したら時間かかるし、ととりあえず車が向いてる方向にまっすぐ車を走らせればガソリンスタンドがあるだろう(こちらのコンビにはガソリンスタンド内にある)、と速攻で車を走らせたんだけど、、、走れど走れどない。。。やばいかも、、、と思い出したころに、やっと、ぱっと開けた店のたくさんある場所について、ガソリンスタンドを発見!パンとポテトチップスを買って、さあ、急いで帰ろう、とガソリンスタンドから出ようと思ったら一方通行。その後、、、右折禁止が何度か続き、、、気がついたら、なんと!シティーセンターに入ってるじゃないですか!シティーセンターといえば地震のせいであちこち通行止め、ほとんどが一方通行、右折禁止の方向音痴には世田谷より恐ろしい地域(笑)あ、こりゃもうだめだ、多分間に合わない、とおなかをすかせたみかんをうらみつつ笑前の車に続いて車を走らせていき、やっとのことで帰り道に出ることが出来、会場に帰ってきました。駐車場も取られちゃってて、遠くに止めて走って会場に帰ると、、、みかんちゃん名前呼ばれて用意しに行ったよー、だって。。。がっくし笑でも、よかった、セミファイナルに選ばれたんだ!セミファイナルは、Juniorの小さい子達とみかんたちとが一緒になって行われたんだけど、、、やっぱり親ばかな私は、みかんより上手な子が何人いるかを数え。。。笑少なくとも5番目以内には入るはず、と目算をつけましたよ。で、みかんが無事に踊り終え、お姉さんたちも終わり、その後さらに、シニアたちのパフォーマンスがあり、やっとのことで結果発表!結果は、、、なんと何との敗退でした!14人中10人ファイナル行ったのにだめだった。。。正直、私もみかんも、お友達もお友達のママも、、、みかんは凄く上手だったのに何で!?と納得できず、、、。お友達なんて、みかんのことが大好きで、みかんに追いつきたい、と凄くあこがれてくれちゃってるのでみかんちゃんのほうが上手だったのにって泣いちゃったんですよ!でもね、翌日に理由がわかったんですが、上手、下手、じゃなくて、今持ってる力をいかにすべて発揮しているかどうか、で採点したんだって。あー、そうなのかあ。確かにあれだけレベルの違う子達をどうやって採点するのかなって思ってたんですよね。それなら納得。つまりみかんは、もうちょっと伸びる余地があるってことよね(前向きすぎ?笑)結果をレポートでいただいたんだけど、その中には悪い理由は書いてなかったけど、その理由を聞けてよかったです。みかんはしばらく、あのこの方がずっとうまく出来ないのに、とか怒ってたんですが、帰り道、明日のファイナルはもう出なくていいんだよといったとたん(理解できてなかったらしい)勝ちたかった。。。と泣きじゃくりました。。。そもそも、この大会するときに、クラスで一番を決めるらしいよって言ったら、とにかく負けず嫌いで、トランプとかですらしたくないみかんは、「えー!そんなことしなくていいのに!」って言ってたからね笑でもそうやっていつも逃げるから(学校でも一言目に、出来ませんって言うらしくて先生に注意されたんだけど)、がんばってトライして、負けて悔しい思いしてっていうこの経験も大事だったよね。しかも!ママが言うとおり、むちゃくちゃ練習したら頭が真っ白になっても体が動いたよ!とのこと。そうなんだ!ママがそう言ってたから信じて、たくさん練習したんだ!もしかして先日飽きずに練習し続けたのは真っ白になっても大丈夫なように?って聞いたところ、そうだよ!だってママが言ってたんだもん。とのこと。うわあ、うれしい!そういうこと、今の年で身をもって経験できるってすばらしいことだよね。負けても大収穫だったなあ!と私はものすごく暖かい気持ちになったのでした。帰り道に、泣き顔を家族に見られたくない強がりなみかんのために、お店に立ち寄ってジュースを買ってねぎらって、泣き止んだところで帰宅したところ、もうすでにりんごもぶどうくんも就寝してました。作ってあったポトフを食べて、みかんはシャワーを浴びてベッドに入ったらもう11時でした。ブログランキングに登録してみました。 よかったらポチっとしてみてください(^^ ↓ にほんブログ村
2014年06月10日
コメント(2)

6月4日 今日は、毎週朝通っていたコーラス隊の発表会の日。 大きなホールで数校集まってコンサートをするんです。 朝リハーサルがある、とのことで8時25分に集合で大急ぎ。 りんごもみかんもぶどうくんも変な咳してたけど、熱はないので、ゴーサイン出しちゃいました(^^; 双子を学校に送った後私は事務所へ。 ぶどう君の必要書類を提出し、クラスが決まったら担任から連絡が来ます、とのこと。 登校の前にならし保育みたいなのを二日行かないといけないそうで、その日程を決めないといけないらしい。 その後ぶどうくんを幼稚園へ送ると、先日2ドル徴収されたお金が返ってきて、、、 昨日の予定だったけど、こなかったから、とのこと。 なんと救急車が来てたんだって!うわあ、それはショック! その後大学へ行き、先生が朝のうちに会議をしようといってたので、プロポーザルを直しつつ待ってたけど さっぱり呼びにこない。。。 そうこうしてるうちに11時に。実は、、、せっかくのコンサートなのに、、、 銀行にお金が入ったらチケットを買おうと思ってたら、、、買い忘れて! 昨日夜見たらもう売り切れてて(涙)、家族チケットはあったんだけど、私一人のために 4人分買うのもお金ないのにばからしいから、、、と11時から始まる電話予約の受付に聞いてみようと思ったんですよね。 そしたら、やっぱり、もう売り切れ、といわれ。。。当日券がある可能性もある、ということ。 でもないかもだよねー。アー、ショック。 一応最後の足掻きで、いつもお世話になってる双子の英語の先生に、誰か余ってる人がいたら 教えてくださいってメールをしました(^^; しばらくして返事が来て、、、もしかしたら6時半より前に行けば買えるかもしれないとの事!!! よかったー!!! お昼後は、プロポーザル直しをしてるうちにもう帰る時間。 帰りぎわにラボの先生に会ったので、培地って滅菌後どのくらい放置していいのかを聞いたところ 今まで仲間に聞いたときはその日のうちにしないといけないんじゃないかなとか言われて わざわざ、りんごを迎えに行った後帰ってきてたわけですが、数日置いておいていいんだそうな! なあんだ、じゃあうまく時間を使って出来そうだわ。 いつものように4時に帰って旦那さんと交代。 お友達のお迎えが5時半にあり、おにぎりやら水を用意して、髪の毛をきれいに結んであげて、とうとうコンサートへ。 チケットは、、、売ってました!よかったー! その後しばらく待ち、子供たちと別れて私たちは会場へ。 台湾のママとおねえちゃんと一緒に座って開演を待ちました。 7時半にやっと開演。子供たちはなんと400人ほど、写真を撮る台のようなところに学校ごとに 座ってました。 三人のプロの歌手がトークも受け持って普通に楽しいコンサートで、子供たちは大きな振り付けで 楽しそうに歌ってましたよ。 プロの歌手は本当に上手だった! 途中ソロの子達が出てきて歌ったんだけど、彼ら、学校でソロとして選ばれた後さらに リハーサルでオーディションがあったらしく、、、ほんとに数人だったんだけど、うまくてびっくり! 中でも双子と同じクラスのSちゃんは顔もかわいくて運動神経抜群なのに(関係ないか笑) 歌がめちゃくちゃうまくて一声歌ったらうわー!って拍手が起こるほど。 ぶどうくんにはつまらなかったようで、ずっとアイパッドで遊んでましたが、 親は、高いなーと思ってたチケットの価値がわかった、位楽しいコンサートでした。 9時過ぎにやっと終了し、双子をピックアップして、大渋滞の駐車場からやっと抜け出し 家に到着したのはもう10時。 旦那さんがチャーハンをそこから作ってくれて、待ってる間にりんごは寝ちゃって、 車で寝ていたぶどうくんは目が覚めてしまって、結局全員寝たのは11時半。 明日、起きられるのかしら? ブログランキングに登録してみました。 よかったらポチっとしてみてください(^^ ↓ にほんブログ村
2014年06月06日
コメント(0)

6月3日 今日は朝起きたら旦那さんも私もぶどうくんもおなかが痛くて。。。 うーん、みかんが吐いたものにやっぱりウイルスが入ってたかな。。。 ぶどうくんはおなかいたいし、ねつもあるかも、というので熱を測ると、38度!あらら。。。 ぶどうくんはお休みにして、子供たちは旦那さんが送っていき私も出発。 その前に、小学校へ。 ぶどう君、来月から小学校♪とか言ってたけど、小学校に何も連絡してないことに気がついたんですよね笑 日本なら自動的に決まるけど、こっちは言わないといけなそうじゃない!? それで小学校へ行ったら、申込書をいただいて、出生証明書(翻訳した戸籍謄本かな)、パスポート、 予防接種の記録が必要だって言われました。 双子のときはいらなかったんだけど、、、あの時は忘れてただけなのかも!? かかりつけ医で日本の記録を渡してあるので、かかりつけ医に電話したところ、すぐにコピーしてくれるそう。 それらをすぐに出してくれたらクラスとかを決めるから急いでくださいって言われましたよ。 ビザも学生ビザに変えないといけないし(3月に変えたのに、また25000円も払うのいやだけど。。。) のんびりしてる場合じゃなかった! そして大学へ行き、大量のデータを書き込んだらもうお昼。 リサーチプロポーザルを先生が訂正してくれたのが出来上がったので、その後はそれをやりつつ、 もう帰る時間に! 今日から4日連続であるのは、みかんのバレエの大会。 レベルごとに4つのグループに別れ、みかんのグループは14人で、予選、準決勝戦、決勝戦、とあるんですよね。 もともと予定のあった水曜日は、奇跡的にみかんの出ないといけないものはないため出られることになり 今日は初日の予選! りんごの送り迎えもあるので、綿密な計画を立て、今日は私がみかんを迎えに行って髪の毛とお化粧をして連れて行くことに。 5時半前には到着したので、前のレベルの子達の大会を二人で見ましたが、 普段やってる、一つ一つの基本の形の練習→本番、とやってました。練習も点数に入るよう。 やるべきことがわかったところで みかんの番。 みかんによれば、前のレベルの子達、の中には、みかんと同じクラスの子達も含まれてるそうで みかんの受けるレベルのほうには、上のレベルの子達も入って、全体的に年齢が高いグループでした。 みかんたちのグループは練習が少なくて、これをやると、とちょっと形を思い出すように練習して 本番、という感じ。 みかんは、やっぱり表現力は最高に上手だけど足捌きがまだまだだなあ。 ステップとかすると、芯はぶれなくなっても、ちょっともたつく感じ。 この回では勝てるかもしれないけど、次のセミファイナルではどうかなあ? 今日は結果は出ないようで、さらに上のクラスの子たちが大会をするのを観察して終わりになりました。 上の子たちがやってるときに、りんごと一緒にジムをやってるお友達がみかんともバレエで同じクラスで 仲良しなんだけど、二人で一緒にバックステージへ駆けていったから、何遊んでるのかなって思ってたんだけど なんと二人で練習してたんだって!まじめだなあ! 疲れたー、おなかすいたー、とへろへろなみかんをつれて帰宅すると、レトルトカレーが用意してあったので それを食べもう9時なので、明日も早いから!と急いで就寝したのでした。 ぶどう君は熱はよくなったみたいだけど、りんごもぶどうくんもへんな咳をしていて、、、 明日、大丈夫かなあ。。。 ブログランキングに登録してみました。 よかったらポチっとしてみてください(^^ ↓ にほんブログ村
2014年06月05日
コメント(2)

6月2日 今週は恐ろしく忙しい、昼も夜も分刻みの生活の予定なんだけど、、、皆咳してる。。。 大丈夫かいな。。。今日はクイーンズバースデーでお休みなので、 夕方まではのんびり過ごし、部屋も片付けさせて、4時からはみかんの発表会のリハーサル。 本番は、高すぎて(笑)、私しか行かないので今日は皆で見に行きました。 本人、木曜日の分は踊りが不安だ、というので、ビデオも撮りましたよ。 ていうかリハーサルのお知らせ、土曜日にもらったんだけど! 今日あいてて良かったわ。。。。 一時間前ぐらいに到着してしまって、4時まで待っていたんだけど、その後もほかの曜日の子の リハーサルがなかなか終わらずかなりまち、ようやく開始。 最初は小さい子達の分。バックステージツアー、みたいに先生がバックステージを案内することから 始まったんだけど、相変わらず幼稚園の小さい子組みたいな、赤ちゃんみたいな子達が、 先生に付き添われて場所を把握して、いわれるとおり一度練習して、リハーサルをすると、 カオスからちゃんとした踊りに変わるのが不思議。先生の力ですね。 その次はみかんたち。まずは木曜日の分だったんだけど、、、一回しか行ってないのに、覚えてるじゃん!凄いな、みかん。 後で聞いたところによると、周りを見ないで、音楽を聴いてカウントして、このカウントでこの動き、って 覚えてるんだって。 エー、それ、りんごに教えてあげてよ!って旦那さんと思わず声がそろいましたよ笑 木曜日の子達は小さい子達なので、みかんがお姉さんなのは当たり前なんだけど、 なんというか体つきが幼児体形から少女の体形に変わり、凄くお姉さんになったなあ、と感じました。 そして、12月に見た発表会のときよりもずーっとずーっと上手になってた。 あのころは、表現は上手だったんだけど、体が完全にはついていかなくて、ぶれてたんですよね。 でも今日は何をしても体の芯がぶれず、安定感があった。 相変わらず表現力はぴか一で、イヤー、あの子は女優だよねーって旦那さんと笑っちゃいましたよ。 そして土曜日の分。こちらではAさんの娘ちゃんのEちゃんも一緒。 今回先生が何が凄いかが少しわかった気がしたのは、的確に正しい人に正しい配役や 仕事をあてがうのが上手な気がする。 だからいまいち不安な子がいても、うまくまとまるんだなーって思いましたよ。 そして、みんなやる気があるなあ!と感心したのは、それなりに音楽かけての練習が一度うまくいって 先生が「どうする?もう一度通してやる?」って質問したところ、みんなが「やります!やらせて!」と 口をそろえていったこと。 全員が終わったのは5時半ぐらいだったんだけど、その後明日から始まる大会の練習する?と みかんとあと二人の子が声をかけられて、やる!と練習を始めたみかん。 いつ終わればいいのかわからなかったってのもあるんだけど、なんとみかんは延々1時間以上 練習を続けましたよ!よくがんばるなあ。 終わった後、ぶどう君が、おなかすいたーちゅうかにいきたいー、といい始めたのをきっかけに、 子供たちが、あの美味しい中華に行きたい!と騒ぎ始め、結局二家族で先日の美味しい中華へ行くことに。 やっぱり中華は人数が多いほどよいようで、この間よりも多く種類を頼み、皆満足にたくさん食べたんだけど 払った値段は、高くない中華と同じくらいでした(^^ 帰った後は、私は何もしてなくて見てただけなのに、疲れちゃって。。。笑 子供たちと一緒に就寝しました。 ブログランキングに登録してみました。 よかったらポチっとしてみてください(^^ ↓ にほんブログ村
2014年06月04日
コメント(2)

6月1日 今日は何もない日曜日。いい天気だけど皆体調イマイチのため家でのんびり。でも大学でカウントだけはしないといけなかったので、三人連れて大学へ行って、カウントしてまたもやプリントアウトをして帰ってきました。1時からは、例のスーパーのカードの交換会があるというのでスーパーへ行って見ると、、、テーブルが4つ置いてあって、そこで、適当にその辺にいる人に声をかけて交換する、という凄く原始的なものでした(笑)みんなを見ると、欲しいもの、いらないもののナンバーのリストがきれーに作ってあって大慌てで私もノートに殴り書き。でもごめんなさい、読めないわとかいわれちゃった(笑)おおらか、適当、肥満とよく言われるNZ人だけど、こと私の住んでる地域の人に限りなのかもしれないけど皆スリムで細いし、結構神経質で細かくてってNZ人にばかり出会う気がする。。。はっきり言って私のほうが適当(笑)みなのリストの数字とか細かくてきれいだったもんなあ。でも飛ぶように交換が進み、最初は物怖じしていた双子も次第に新しい人がいると自分から声をかけるようになり後一枚に!この後一枚が結構不足してるもののようで、皆探していて、、、そうこうしていたらスーパーの人が来週もする、というので、また一週間手持ちの余裕札を貯めて交換すればありそうだな、と私は諦めることに(笑)双子はまだ聞く、というので双子に任せて買い物を終えて帰ってくると、そろったよ!とのこと。一人凄くいい加減な感じの女の子がいて、はこに大量にカードを入れて、聞くとざくざくっとさがしてくれてたんですよね。私もあの人は持ってるかもしれないな、って思ったけど、双子もそう思ったそうで、三回も聞きに行ったんだって(笑)そしたら、あら、私持ってたわ!ってくれたんだそう!カードを集めてるわけじゃなくて、次々自分のカードを欲しい人に上げてるおばあさんとかもいていやあ、結構楽しかったですよ(笑)もうそろったけど一週間またそろえて、また来週交換会行っても良いかもって思うくらい楽しかったです(笑)帰宅後は昼食にお好み焼きを食べた後、またCD作りに励むうちに一日が終了。あ、そうそう、今日はぬかどこを作りましたよ。美味しくできますように!夕食は、鳥鍋。大量に野菜入れたけどあっという間にすっからかんに。そして夜中、寝入りばなのみかんが、いつものように気管につばを詰まらせて咳き込んだところ(これ、多分私の遺伝。私もいつもつばが気管に入って苦しむんですよね、小さいころから。。。)そのまま吐いた!ぶどうくんが汚れないようにガードしてる間に旦那さんにトイレに連れてってもらったら何を思ったか、廊下に戻ってきてまた吐いた(笑)あちこち大掃除ですよ(^^;風呂で洗って出てきたみかんは落ち着いてて、別に気持ち悪くなかったのになんでかな、と。うーん、咳き込みすぎ?または胃腸風邪?先週は私もだんなさんもおなかの調子がひどく悪かったからなあ。ブログランキングに登録してみました。 よかったらポチっとしてみてください(^^ ↓ にほんブログ村
2014年06月03日
コメント(2)

30日 今日はいつものように子供たちを送ってから大学へ。まずは昨日夜最後にプレートを作ろうと思ったらまだ滅菌が出来上がってなくて諦めたのでプレートを作ろうと思ってたんだけど、滅菌今してる、とのことで、昨日畑に貰いにいった野菜をやるべく準備開始。その後サンプルを用意したんだけど、プレートが足らなかったので、しょうがなく、滅菌が出来るまで時間つぶし。久々にパソコンの前に座って、結果を打ち込んだりしてるうちにお昼ご飯に。お昼を食べて、やっと滅菌が出来上がったので、プレートを準備し、実験をし、昨日の分をカウントし終わったらもう帰る時間!慌ててりんごを迎えに行きました。その後買い物して帰宅して今日はりんごのリクエストでさいころステーキに。ぶどうくんは、プールで先生から凄く上手になったから次から上のクラスねって言われたんだって!おお!早いなあ。そうそう、昨日みかんはバレエのピンチヒッターにいったわけなんだけど、よくよく考えたら、もう発表会は来週。。。ピンチヒッターで一度しか練習しないってこと!?本人も、他のやつはいいけど、木曜日の分が覚えられるか不安だ、とのこと。そりゃそうだよなあ。リハーサルでビデオ撮らなくちゃ・・・あ、そうそう、今回はなんと、ソロがあるらしいですよ!楽しみ♪31日 今日は朝バレエに送った後いつものようにりんごとぶどうくんを連れて大学へ。昨日の分をカウントしようと思ったんだけど、やっぱり凄い量で、、、1時間半もかかった!りんごはパソコン、ぶどうくんはアイパッドをやっておとなしく待っていてくれたので急いでペーパークラフトをプリントしていったん家へ。ラーメンやらサンドイッチやらを用意して、旦那さんに作っておいて貰ったおにぎりもってみかんをピックアップして出かけようと思ったんだけど、バレエが終わったみかんは、具合が悪い、と。朝もちょっと具合が悪かったので体温計を持ってきていたんだけど、測ってみたら38度で!しょうがないので、りんごとパパだけ今期最後の百姓講座に出かけていきました。私たちは、行きたいけど時間がないなあと思ってた近所の教会のブックセールに行きましたよ。今回は英語の事典を主に探したんだけど、いい本がいっぱいあったー!キッズは一冊50セントだったのに、凄く得した気分ですよ♪(写真は先日のサイエンスの本二冊も入ってます)ぶどうくんがこのビーバーのおうちがお気に入り↓私はこの双子や出産の絵に感心!↓この食虫植物もぶどう君のお気に入り↓特にぶどうくんが、Natureの本が凄く気に入って。動物の巣や、体の仕組み、植物の中身などが全部凄くわかりやすく断面図で書いてあって面白い!みんなが帰ってくるまで本を皆夢中で読んでました。夜ご飯は、具沢山炊き込みご飯と大量野菜のスープに。どっちも美味しくてぶどうくんは一週間分くらい野菜を食べてくれました(笑)百姓講座のほうは収穫物でけんちん汁を食べて美味しかったし楽しかったそうですよ。夜は皆で早々に就寝してしまいました。 ブログランキングに登録してみました。 よかったらポチっとしてみてください(^^ ↓ にほんブログ村
2014年06月02日
コメント(2)
28日 今日は朝ぶどうくんがすごく熱くて、休む、というので、休むことにして双子を学校へ送り いったん帰ってシャワー浴びてたんだけど、なんか元気になってきたようで、幼稚園に行く!と いって聞かない。。。 あまりに聞かないので連れて行ってみたところ、熱が一度あったなら一日休んで、といわれて かえされちゃいました。ま、そうよね。 そして10時からは予約していた銀行へ。 とうとう後二月持つはず手元のお金が全くなくなってね。。。。 日本円を両替してきましたよ。。。 アー、どんどんお金が少なくなってくる。。。 就職できないともう二年ももたないな。。。 できたとしても私の給料で、マイナスにならないように暮らせるのかかなーり不安ですよ。。。 不安にさいなまれつつ大学へ行き、午前中はパソコンであれこれ仕事して、 お昼後に昨日の分をカウント。うん、とてもいい感じ! じゃあ、明日には買ってきた野菜を全部やろう!ということになりました。明日は忙しそうだ! その後もパソコンをして帰宅すると、今日はお友達は来なかったようで、みんなだらだら過ごしてました。 旦那さんが学校へ行って夕食は豚のひき肉を使ってごった煮。おいしかった。 先日丘のお宅で、お姉ちゃんがもう使わなくなった、水で描く書道のセットを頂いてきたんだけど子供たちがそれにはまって、パパも珍しくやり方を上手に教えてくれたんだそうで、一生懸命練習してました。進研ゼミのパッドが来て以来、一生懸命進研ゼミに励む二人なんですが、補習校のときはもう日本語がいやでいやでしょうがなかったのに、最近は日本語が楽しくなってきたんだって。筆もやりたいし、漢字も書きたくなってきたそう。そんなに気持ちで違うんだなあってびっくりですよ。 29日 今日は忙しい一日!まずは双子を送って家に帰り、ぶどうくんを送って幼稚園へ。来月大きい子だけで遠足があるんだって。今からだの勉強をしてるから、博物館へ行って体の展示を見てくるんだそうな。そうそう、先日、幼稚園の角のところに暗い怪しいスペースが作られたなーって思ったらそこ、診察室になったんですよね!本物のレントゲン写真が窓にいっぱい貼り付けられてるの!(笑)面白いなーって思ってたけど、そこで体の遊び兼勉強をしてたらしい。ぶどう君いわく、ここにも書いてあるよ!というので見てみると、Aのつく単語、が書いてあってアンビュランスがあるんだよ!とのこと。おお、知らない間に勉強もしてたのか。。。ぶどうくんを置いて大学へ行き、今日は朝からラボへ。今日やるべきプレートにまず名前をかこうと思ったんだけど、、、計算してみたら凄い量!なんと180個もある!やっと書き終えたらもう11時過ぎてましたよ。。。これじゃ先日作ったプレートがなくなっちゃう、と、実験の前に再び寒天をたくさん作成し、サンプルを少し作ったところでお昼ご飯。10分で済ませて、更にサンプルをつくり、次はいつもの畑へ。今日は畑の主がいないから、自分で取ってね、と前回取り方を教わっていたので、やってみましたよ!難しい!ほうれん草とか、全部赤い部分が切れちゃって葉っぱがばらばらと離れちゃうし、キャベツはどれが大きいのかよくわからないし、そもそも、ほら、無農薬だから雑草をそのままはやしていてその中に野菜があるので、見つけるのすら苦労しましたよ(^^;再び大学へ戻り、今度は実験開始。結局一度も休まず、トイレも行かず、2時からはじめて、終わったのは7時!ひゃー、大変だった!使い果たしちゃった薬液やいろいろなものを作成して滅菌の部屋へもって行き、ずっとパソコンに向かってないので、たまったメールの返信をしたらもう8時半!帰宅したら、九時前なのに、もう子供たちは全員寝てました! ブログランキングに登録してみました。 よかったらポチっとしてみてください(^^ ↓ にほんブログ村
2014年06月01日
コメント(2)
全25件 (25件中 1-25件目)
1
![]()
![]()
